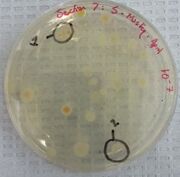

Uploads by April Rose Schattner
From OpenWetWare
Jump to navigationJump to search
This special page shows all uploaded files.
| Date | Name | Thumbnail | Size | Description |
|---|---|---|---|---|
| 21:07, 19 March 2015 | Caffeine9121.jpg (file) |  |
40 KB | |
| 21:06, 19 March 2015 | Caffeine.jpg (file) |  |
40 KB | |
| 21:05, 19 March 2015 | Control12345.jpg (file) |  |
30 KB | |
| 01:40, 4 March 2015 | Screenshot 1.png (file) |  |
345 KB | |
| 16:54, 14 February 2015 | Coelmate image.jpg (file) |  |
25 KB | |
| 16:53, 14 February 2015 | Coelmate diagram.jpg (file) |  |
76 KB | |
| 16:23, 14 February 2015 | Chilopoda.2.12.2015.jpg (file) |  |
37 KB | |
| 16:22, 14 February 2015 | Arachnida.2.12.2015.jpg (file) |  |
38 KB | |
| 16:21, 14 February 2015 | Crustacean.2.12.2015.jpg (file) |  |
17 KB | |
| 16:20, 14 February 2015 | Diplopoda.2.11.2015.jpg (file) |  |
41 KB | |
| 16:19, 14 February 2015 | Insect.2.12.2015.jpg (file) |  |
28 KB | |
| 03:03, 13 February 2015 | IMG 2159.jpg (file) |  |
51 KB | |
| 02:55, 13 February 2015 | IMG 4245.jpg (file) |  |
46 KB | |
| 02:50, 13 February 2015 | IMG 4244 (1).jpg (file) |  |
24 KB | |
| 02:49, 13 February 2015 | IMG 4243.jpg (file) |  |
37 KB | |
| 02:41, 13 February 2015 | Plant -1.jpg (file) |  |
30 KB | |
| 02:34, 13 February 2015 | Plant -2.jpg (file) |  |
25 KB | |
| 13:50, 6 February 2015 | Aschattnertet12.jpg (file) |  |
37 KB | |
| 13:48, 6 February 2015 | Aschattnernut12.jpg (file) | |
31 KB | |
| 13:40, 6 February 2015 | Aschattnertet2.jpg (file) |  |
66 KB | |
| 13:37, 6 February 2015 | Aschattnertet1.jpg (file) |  |
61 KB | |
| 12:51, 29 January 2015 | April Schattner - Observations by roots.jpg (file) |  |
60 KB | |
| 12:47, 29 January 2015 | April Schattner - Observations by soil.jpg (file) |  |
81 KB | |
| 12:01, 29 January 2015 | April Schattner Transect 5 Diagram.jpg (file) |  |
74 KB | |
| 11:56, 29 January 2015 | Transect 5 Diagram.jpg (file) |  |
74 KB |